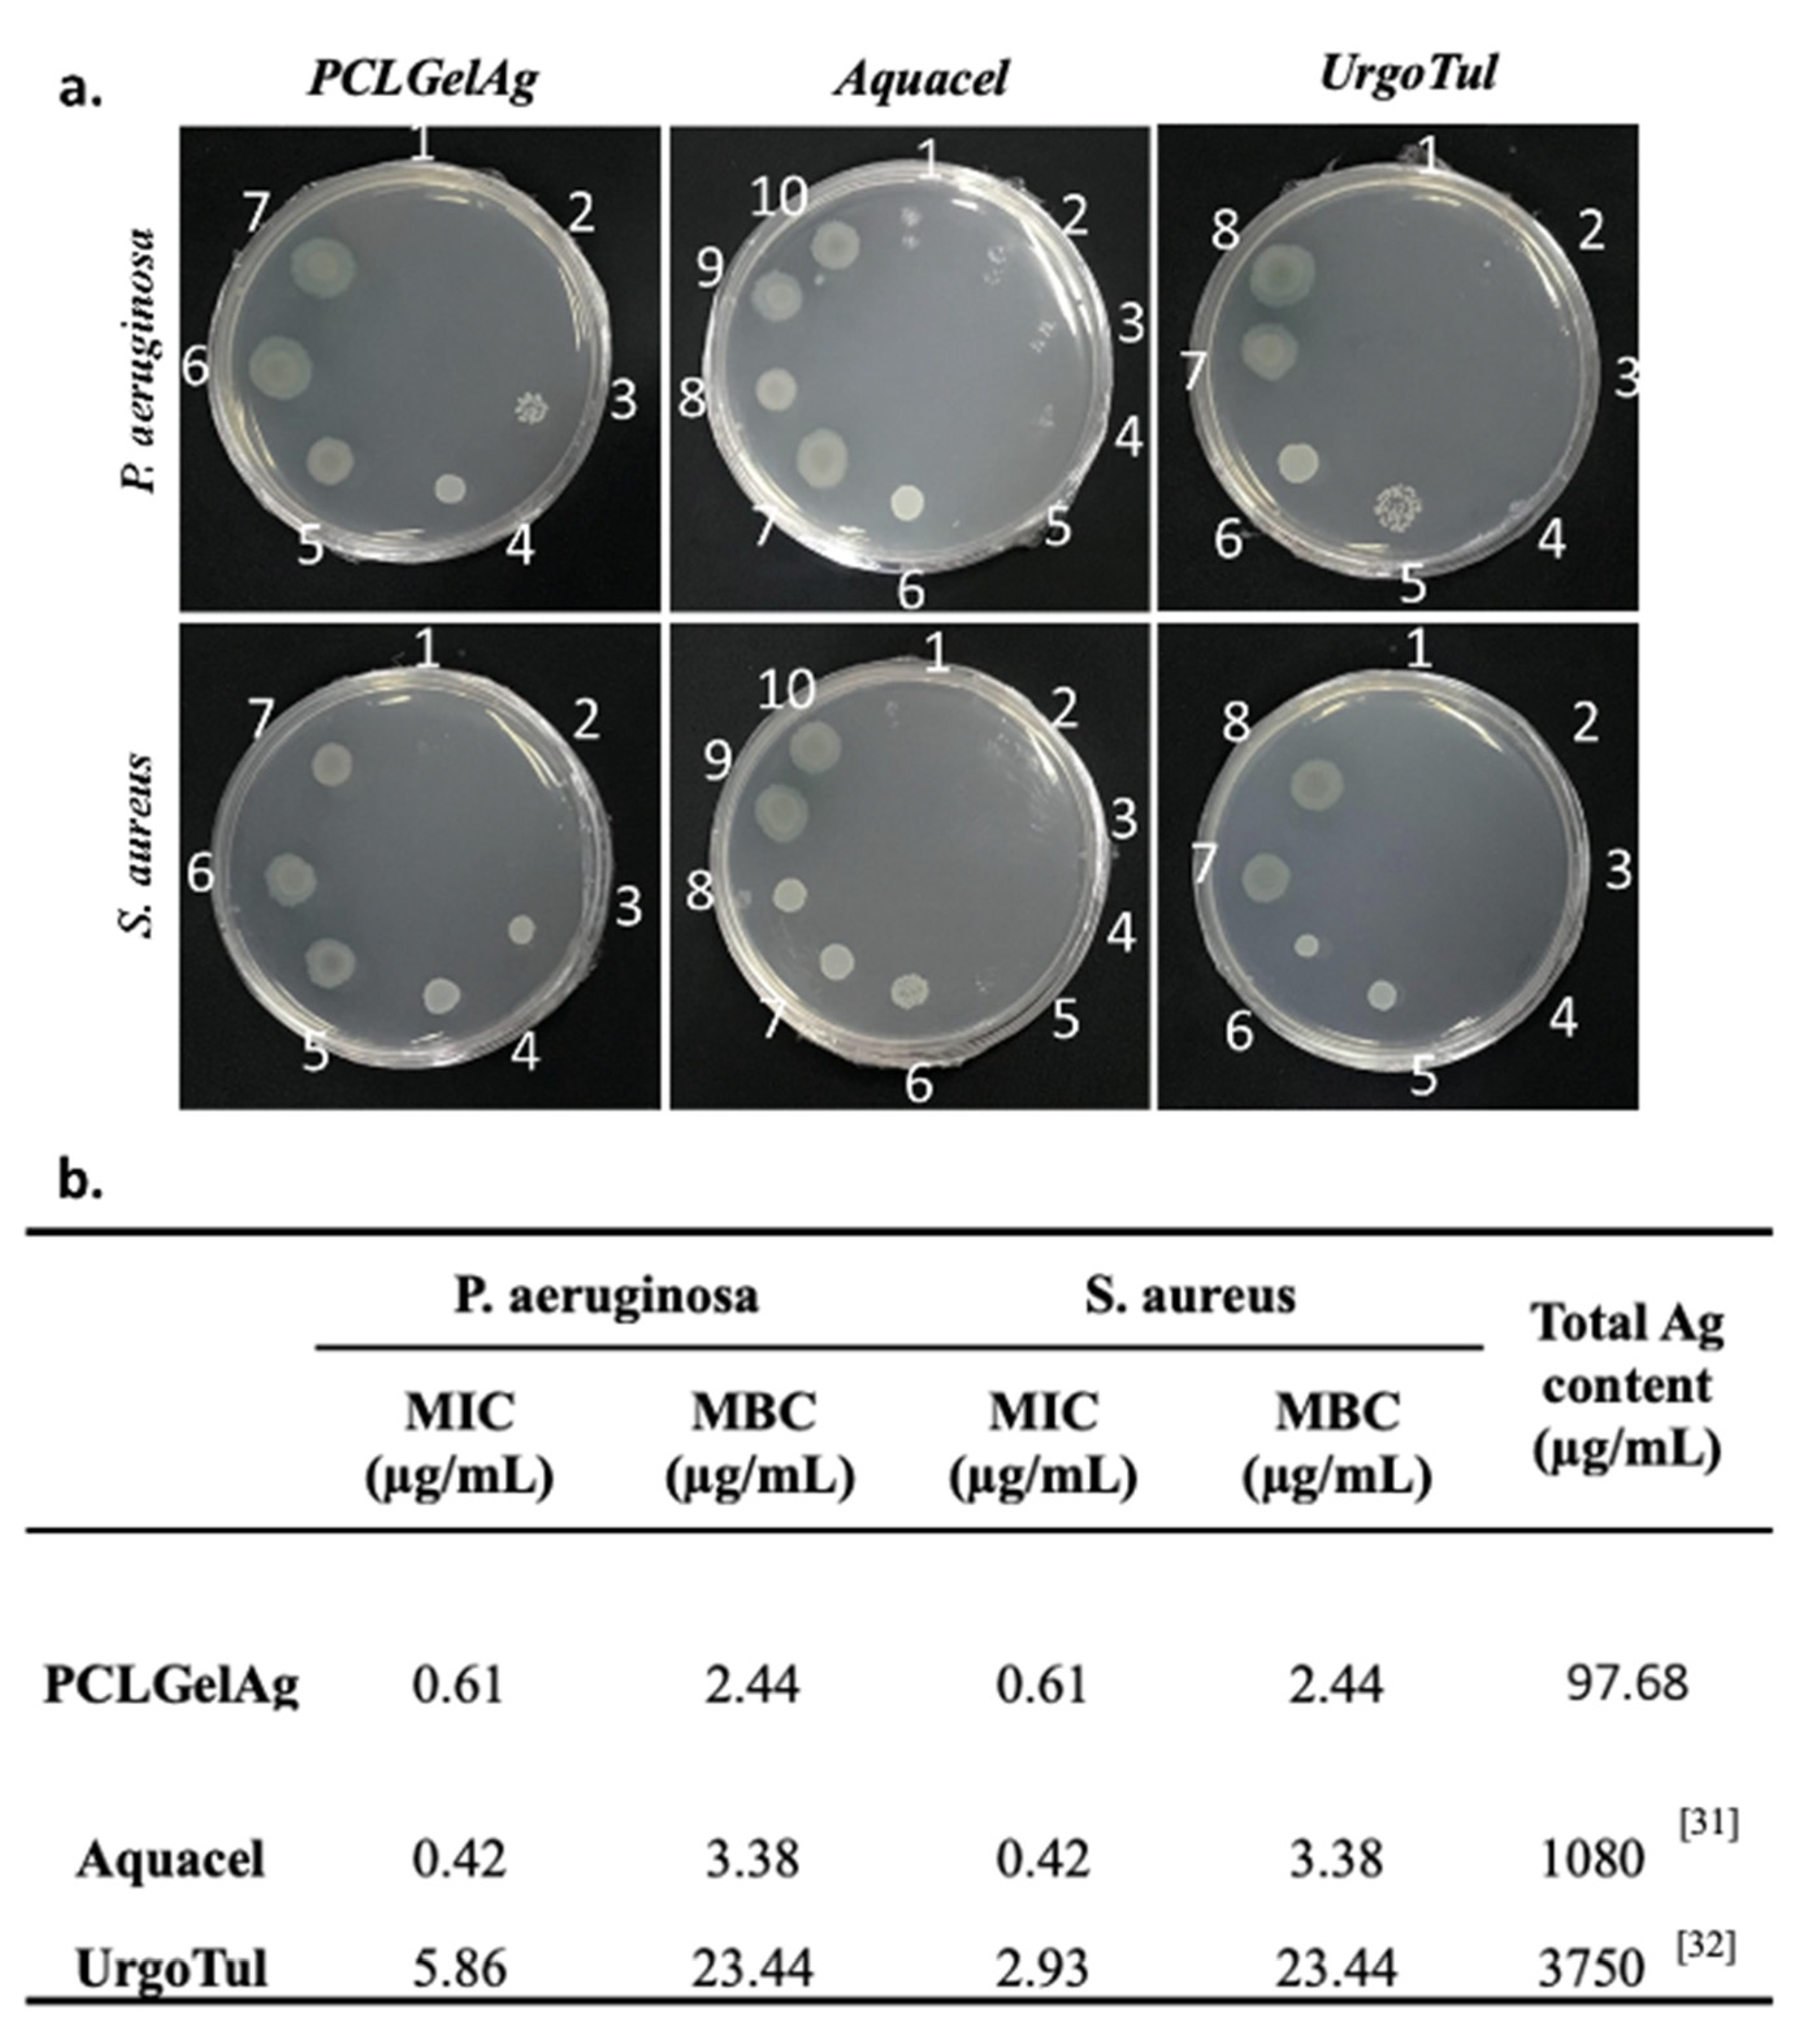
Polymers 13 03116 g005 Polymers 13 03116 g005

The Efficacy of Silver-Based Electrospun Antimicrobial Dressing in Accelerating the Regeneration of Partial Thickness Burn Wounds Using a Porcine Model
Abstract
1. Introduction
2. Materials and Methods
2.1. Material
2.2. Antibacterial Activity
2.2.1. Agar Diffusion
2.2.2. Broth Microdilution Method
2.2.3. Time-Kill Assay
2.3. In Vivo Study
2.3.1. Burn Device
2.3.2. Creation of Burn Wounds in A Porcine Model
2.3.3. Wound Closure Observation
2.3.4. Histological Analysis
2.4. Statistical Analysis
3. Results
3.1. Agar Diffusion
3.2. Broth Microdilution Method
3.3. Time-Kill Assay
3.4. Wound Closure Observation
3.5. Histology Analysis
4. Discussion
5. Conclusions
Author Contributions
Funding
Institutional Review Board Statement
Informed Consent Statement
Data Availability Statement
Acknowledgments
Conflicts of Interest
References
- Alemayehu, S.; Afera, B.; Kidanu, K.; Belete, T. Management Outcome of Burn Injury and Associated Factors among Hospitalized Children at Ayder Referral Hospital, Tigray, Ethiopia. Int. J. Pediatr. 2020, 2020, 9136256. [Google Scholar] [CrossRef] [PubMed]
- Rowan, M.P.; Cancio, L.C.; Elster, E.A.; Burmeister, D.M.; Rose, L.F.; Natesan, S.; Chan, R.K.; Christy, R.J.; Chung, K.K. Burn wound healing and treatment: Review and advancements. Crit. Care 2015, 19, 243. [Google Scholar] [CrossRef] [PubMed]
- Church, D.; Elsayed, S.; Reid, O.; Winston, B.; Lindsay, R. Burn Wound Infections. Clin. Microbiol. Rev. 2006, 19, 403–434. [Google Scholar] [CrossRef] [PubMed]
- Lawrence, J.C.; Bull, J.P. Thermal Conditions which Cause Skin Burns. Eng. Med. 1976, 5, 61–63. [Google Scholar] [CrossRef]
- Nielson, C.B.; Duethman, N.C.; Howard, J.M.; Moncure, M.; Wood, J.G. Burns: Pathophysiology of Systemic Complications and Current Management. J. Burn Care Res. 2017, 38, e469–e481. [Google Scholar] [CrossRef]
- Wang, Y.; Beekman, J.; Hew, J.; Jackson, S.; Issler-Fisher, A.C.; Parungao, R.; Lajevardi, S.S.; Li, Z.; Maitz, P.K. Burn injury: Challenges and advances in burn wound healing, infection, pain and scarring. Adv. Drug Deliv. Rev. 2018, 123, 3–17. [Google Scholar] [CrossRef]
- Evers, L.H.; Bhavsar, D.; Mailänder, P. The biology of burn injury. Exp. Dermatol. 2010, 19, 777–783. [Google Scholar] [CrossRef]
- Jeschke, M.G.; Van Baar, M.E.; Choudhry, M.A.; Chung, K.K.; Gibran, N.S.; Logsetty, S. Burn injury. Nat. Rev. Dis. Primers 2020, 6, 11. [Google Scholar] [CrossRef]
- Shakespeare, P. Burn wound healing and skin substitutes. Burns 2001, 27, 517–522. [Google Scholar] [CrossRef]
- Spanholtz, T.A.; Theodorou, P.; Amini, P.; Spilker, G. Severe burn injuries: Acute and long-term treatment. Dtsch. Ärzteblatt Int. 2009, 106, 607–613. [Google Scholar] [CrossRef]
- Dai, T.; Huang, Y.; Sharma, S.K.; Hashmi, J.T.; Kurup, D.B.; Hamblin, M.R. Topical antimicrobials for burn wound infections. Recent Pat. Anti-Infect. Drug Discov. 2010, 5, 124–151. [Google Scholar] [CrossRef]
- Gunasekaran, T.; Nigusse, T.; Dhanaraju, M.D. Silver Nanoparticles as Real Topical Bullets for Wound Healing. J. Am. Coll. Clin. Wound Spec. 2011, 3, 82–96. [Google Scholar] [CrossRef]
- Zhong, W. Efficacy and toxicity of antibacterial agents used in wound dressings. Cutan. Ocul. Toxicol. 2015, 34, 61–67. [Google Scholar] [CrossRef]
- Filipović, U.; Dahmane, R.G.; Ghannouchi, S.; Zore, A.; Bohinc, K. Bacterial adhesion on orthopedic implants. Adv. Colloid Interface Sci. 2020, 283, 102228. [Google Scholar] [CrossRef]
- Murphy, P.S.; Evans, G.R.D. Advances in Wound Healing: A Review of Current Wound Healing Products. Plast. Surg. Int. 2012, 2012, 190436. [Google Scholar] [CrossRef]
- Carsin, H.; Wasserman, D.; Pannier, M.; Dumas, R.; Bohbot, S. A silver sulphadiazine-impregnated lipidocolloid wound dressing to treat second-degree burns. J. Wound Care 2004, 13, 145–148. [Google Scholar] [CrossRef][Green Version]
- Heyneman, A.; Hoeksema, H.; Vandekerckhove, D.; Pirayesh, A.; Monstrey, S. The role of silver sulphadiazine in the conservative treatment of partial thickness burn wounds: A systematic review. Burns 2016, 42, 1377–1386. [Google Scholar] [CrossRef]
- Nowack, B.; Krug, H.F.; Height, M. 120 Years of Nanosilver History: Implications for Policy Makers. Environ. Sci. Technol. 2011, 45, 1177–1183. [Google Scholar] [CrossRef]
- Khansa, I.; Schoenbrunner, A.R.; Kraft, C.T.; Janis, J.E. Silver in Wound Care—Friend or Foe? A Comprehensive Review. Plast. Reconstr. Surg. Glob. Open 2019, 7, e2390. [Google Scholar] [CrossRef]
- Wasef, L.G.; Shaheen, H.M.; El-Sayed, Y.S.; Shalaby, T.; Samak, D.H.; El-Hack, M.E.A.; Al-Owaimer, A.; Saadeldin, I.; El-Mleeh, A.; Ba-Awadh, H.; et al. Effects of Silver Nanoparticles on Burn Wound Healing in a Mouse Model. Biol. Trace Elem. Res. 2020, 193, 456–465. [Google Scholar] [CrossRef]
- Galandáková, A.; Frankova, J.; Ambrozova, N.; Habartová, K.; Pivodová, V.; Zálešák, B.; Šafářová, K.; Smékalová, M.; Ulrichova, J. Effects of silver nanoparticles on human dermal fibroblasts and epidermal keratinocytes. Hum. Exp. Toxicol. 2016, 35, 946–957. [Google Scholar] [CrossRef]
- Nguyen, T.D.; Nguyen, T.T.; Ly, K.; Tran, H.; Nguyen, T.T.N.; Vo, M.T.; Ho, H.M.; Dang, N.T.N.; Vo, V.T.; Nguyen, D.H. In Vivo Study of the Antibacterial Chitosan/Polyvinyl Alcohol Loaded with Silver Nanoparticle Hydrogel for Wound Healing Applications. Int. J. Polym. Sci. 2019, 2019, 7382717. [Google Scholar] [CrossRef]
- Ramadhan, M.A.K.; Balasm, A.N.; Kadhem, S.B.; Al-Saedi, H.F. Effect of Silver Nanoparticles on Healing of Third-Degree Burns Infected with Pseudomonas Aeruginosa in Laboratory Mice. Maced. Vet. Rev. 2020, 44, 17–28. [Google Scholar] [CrossRef]
- Pang, S.; Gao, Y.; Wang, F.; Wang, Y.; Cao, M.; Zhang, W.; Liang, Y.; Song, M.; Jiang, G. Toxicity of silver nanoparticles on wound healing: A case study of zebrafish fin regeneration model. Sci. Total Environ. 2020, 717, 137178. [Google Scholar] [CrossRef] [PubMed]
- Iljas, J.; Röhl, J.; McGovern, J.; Moromizato, K.; Parker, T.; Cuttle, L. A human skin equivalent burn model to study the effect of a nanocrystalline silver dressing on wound healing. Burns 2021, 47, 417–429. [Google Scholar] [CrossRef] [PubMed]
- Thanh, N.T.; Hieu, M.H.; Phuong, N.T.M.; Thuan, T.D.B.; Thu, H.N.T.; Thai, V.-P.; Minh, T.D.; Dai, H.N.; Vo, V.T.; Thi, H.N. Optimization and characterization of electrospun polycaprolactone coated with gelatin-silver nanoparticles for wound healing application. Mater. Sci. Eng. 2018, 91, 318–329. [Google Scholar] [CrossRef] [PubMed]
- Ho, M.H.; Do, T.B.-T.; Dang, N.N.-T.; Le, A.N.-M.; Ta, H.T.-K.; Van Vo, T.; Nguyen, H.T. Effects of an Acetic Acid and Acetone Mixture on the Characteristics and Scaffold–Cell Interaction of Electrospun Polycaprolactone Membranes. Appl. Sci. 2019, 9, 4350. [Google Scholar] [CrossRef]
- Nguyen, T.N.; Do, T.B.; Ho, M.H.; Tran, N.M.; Dang, N.N.; Do, T.M.; Nguyen, H.T.; Phan, T.B.; Tran, Q.N.; Van Vo, T.; et al. Investigating the effect of multi-coated hydrogel layer on characteristics of electrospun PCL membrane coated with gelatin/silver nanoparticles for wound dressing application. J. Biomed. Mater. Res. Part A 2021. [Google Scholar] [CrossRef]
- Clinical and Laboratory Standards Institute. Methods for Dilution Antimicrobial Susceptibility Tests for Bacteria that Grow Aerobically. Approved Standard; Clinical and Laboratory Standards Institute: Wayne, PA, USA, 2012; Volume 32. [Google Scholar]
- The Japanese Industrial Standards. Testing for Antibacterial Activity and Efficacy on Textile Products; Japanese Standards Association: Tokyo, Japan, 2002. [Google Scholar]
- Parsons, D.; Bowler, P.G.; Myles, V.; Jones, S. Silver antimicrobial dressings in wound management: A comparison of antibacterial, physical, and chemical characteristics. Wounds 2005, 17, 222–232. [Google Scholar]
- White, R.; Cowan, T.; Glover, D. Supporting Evidence-Based Practice: A Clinical Review of TLC Healing Matrix; MA Healthcare Ltd.: London, UK, 2015; Volume 24, pp. S1–S48. [Google Scholar]
- Summerfield, A.; Meurens, F.; Ricklin, M.E. The immunology of the porcine skin and its value as a model for human skin. Mol. Immunol. 2015, 66, 14–21. [Google Scholar] [CrossRef]
- Debeer, S.; Le Luduec, J.-B.; Kaiserlian, D.; Laurent, P.; Nicolas, J.F.; Dubois, B.; Kanitakis, J. Comparative histology and immunohistochemistry of porcine versus human skin. Eur. J. Dermatol. 2013, 23, 456–466. [Google Scholar] [CrossRef]
- Simões, D.; Miguel, S.A.P.; Ribeiro, M.; Coutinho, P.; Mendonça, A.; Correia, I.J. Recent advances on antimicrobial wound dressing: A review. Eur. J. Pharm. Biopharm. 2018, 127, 130–141. [Google Scholar] [CrossRef]
- Vaughan, J.; Benson, R.; Vaughan, K. Assessing the effectiveness of antimicrobial wound dressings In Vitro. In Advanced Wound Repair Therapies; Farrar, D., Ed.; Woodhead Publishing: Sawston, UK, 2011; pp. 227–246. [Google Scholar]
- Kostenko, V.; Lyczak, J.; Turner, K.; Martinuzzi, R.J. Impact of silver-containing wound dressings on bacterial biofilm viability and susceptibility to antibiotics during prolonged treatment. Antimicrob. Agents Chemother. 2010, 54, 5120–5131. [Google Scholar] [CrossRef]
- Dakal, T.C.; Kumar, A.; Majumdar, R.S.; Yadav, V. Mechanistic basis of antimicrobial actions of silver nanoparticles. Front. Microbiol. 2016, 7, 1831. [Google Scholar] [CrossRef]
- Wilkinson, L.J.; White, R.J.; Chipman, J.K. Silver and nanoparticles of silver in wound dressings: A review of efficacy and safety. J. Wound Care 2011, 20, 543–549. [Google Scholar] [CrossRef]
- Yuan, Y.-G.; Peng, Q.-L.; Gurunathan, S. Effects of silver nanoparticles on multiple drug-resistant strains of staphylococcus aureus and pseudomonas aeruginosa from mastitis-infected goats: An alternative approach for antimicrobial therapy. Int. J. Mol. Sci. 2017, 18, 569. [Google Scholar] [CrossRef]
- Wiegand, C.; Abel, M.; Ruth, P.; Elsner, P.; Hipler, U.-C. In Vitro assessment of the antimicrobial activity of wound dressings: Influence of the test method selected and impact of the pH. J. Mater. Sci. 2015, 26, 18. [Google Scholar] [CrossRef]
- Szweda, P.; Gorczyca, G.; Tylingo, R. Comparison of antimicrobial activity of selected, commercially available wound dressing materials. J. Wound Care 2018, 27, 320–326. [Google Scholar] [CrossRef]
- Rose, L.F.; Chan, R.K. The Burn Wound Microenvironment. Adv. Wound Care 2016, 5, 106–118. [Google Scholar] [CrossRef]
- Gurtner, G.C.; Werner, S.; Barrandon, Y.; Longaker, M.T. Wound repair and regeneration. Nature 2008, 453, 314–321. [Google Scholar] [CrossRef]
- Zhang, K.; Lui, V.C.H.; Chen, Y.; Lok, C.N.; Wong, K.K.Y. Delayed application of silver nanoparticles reveals the role of early inflammation in burn wound healing. Sci. Rep. 2020, 10, 6338. [Google Scholar] [CrossRef]
- You, C.; Li, Q.; Wang, X.; Wu, P.; Ho, J.K.; Jin, R.; Zhang, L.; Shao, H.; Han, C. Silver nanoparticle loaded collagen/chitosan scaffolds promote wound healing via regulating fibroblast migration and macrophage activation. Sci. Rep. 2017, 7, 10489. [Google Scholar] [CrossRef]
- Merrell, J.G.; McLaughlin, S.W.; Tie, L.; Laurencin, C.T.; Chen, A.F.; Nair, L.S. Curcumin-loaded poly(ε-caprolactone) nanofibres: Diabetic wound dressing with anti-oxidant and anti-inflammatory properties. Clin. Exp. Pharmacol. Physiol. 2009, 36, 1149–1156. [Google Scholar] [CrossRef]
- Atiyeh, B.S.; Costagliola, M.; Hayek, S.N.; Dibo, S.A. Effect of silver on burn wound infection control and healing: Review of the literature. Burns 2007, 33, 139–148. [Google Scholar] [CrossRef]
- Liu, X.; Lee, P.-Y.; Ho, C.-M.; Lui, V.C.H.; Chen, Y.; Che, C.M.; Tam, P.K.H.; Wong, K.K.Y. Silver nanoparticles mediate differential responses in keratinocytes and fibroblasts during skin wound healing. ChemMedChem 2010, 5, 468–475. [Google Scholar] [CrossRef]
- Li, C.W.; Wang, Q.; Li, J.; Hu, M.; Shi, S.J.; Li, Z.W.; Wu, G.L.; Cui, H.H.; Li, Y.Y.; Zhang, Q.; et al. Silver nanoparticles/chitosan oligosaccharide/poly(vinyl alcohol) nanofiber promotes wound healing by activating TGFβ1/Smad signaling pathway. Int. J. Nanomed. 2016, 11, 373–387. [Google Scholar] [CrossRef]
- Chowdhury, S.; De, M.; Guha, R.; Batabyal, S.; Samanta, I.; Hazra, S.K.; Ghosh, T.K.; Konar, A.; Hazra, S. Influence of silver nanoparticles on post-surgical wound healing following topical application. Eur. J. Nanomed. 2014, 6, 237–247. [Google Scholar] [CrossRef]

Publisher’s Note: MDPI stays neutral with regard to jurisdictional claims in published maps and institutional affiliations. |
© 2021 by the authors. Licensee MDPI, Basel, Switzerland. This article is an open access article distributed under the terms and conditions of the Creative Commons Attribution (CC BY) license (https://creativecommons.org/licenses/by/4.0/).
Share and Cite
Do, T.B.-T.; Nguyen, T.N.-T.; Ho, M.H.; Nguyen, N.T.-P.; Do, T.M.; Vo, D.T.; Hua, H.T.-N.; Phan, T.B.; Tran, P.A.; Nguyen, H.T.-T.; et al. The Efficacy of Silver-Based Electrospun Antimicrobial Dressing in Accelerating the Regeneration of Partial Thickness Burn Wounds Using a Porcine Model. Polymers 2021, 13, 3116. https://doi.org/10.3390/polym13183116
Do TB-T, Nguyen TN-T, Ho MH, Nguyen NT-P, Do TM, Vo DT, Hua HT-N, Phan TB, Tran PA, Nguyen HT-T, et al. The Efficacy of Silver-Based Electrospun Antimicrobial Dressing in Accelerating the Regeneration of Partial Thickness Burn Wounds Using a Porcine Model. Polymers. 2021; 13(18):3116. https://doi.org/10.3390/polym13183116
Chicago/Turabian StyleDo, Thien Bui-Thuan, Tien Ngoc-Thuy Nguyen, Minh Hieu Ho, Nghi Thi-Phuong Nguyen, Thai Minh Do, Dai Tan Vo, Ha Thi-Ngoc Hua, Thang Bach Phan, Phong A. Tran, Hoai Thi-Thu Nguyen, and et al. 2021. "The Efficacy of Silver-Based Electrospun Antimicrobial Dressing in Accelerating the Regeneration of Partial Thickness Burn Wounds Using a Porcine Model" Polymers 13, no. 18: 3116. https://doi.org/10.3390/polym13183116
APA StyleDo, T. B.-T., Nguyen, T. N.-T., Ho, M. H., Nguyen, N. T.-P., Do, T. M., Vo, D. T., Hua, H. T.-N., Phan, T. B., Tran, P. A., Nguyen, H. T.-T., Vo, T. V., & Nguyen, T.-H. (2021). The Efficacy of Silver-Based Electrospun Antimicrobial Dressing in Accelerating the Regeneration of Partial Thickness Burn Wounds Using a Porcine Model. Polymers, 13(18), 3116. https://doi.org/10.3390/polym13183116

